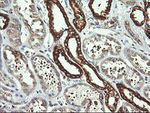
DNM1L Antibody in Immunohistochemistry (Paraffin) (IHC (P))
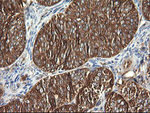
DNM1L Antibody in Immunohistochemistry (Paraffin) (IHC (P))

Search
OriGene
DNM1L Monoclonal Antibody (OTI4B5), TrueMAB™
{{$productOrderCtrl.translations['antibody.pdp.commerceCard.promotion.promotions']}}
{{$productOrderCtrl.translations['antibody.pdp.commerceCard.promotion.viewpromo']}}
{{$productOrderCtrl.translations['antibody.pdp.commerceCard.promotion.promocode']}}: {{promo.promoCode}} {{promo.promoTitle}} {{promo.promoDescription}}. {{$productOrderCtrl.translations['antibody.pdp.commerceCard.promotion.learnmore']}}
产品信息
CF506151
种属反应
宿主/亚型
分类
类型
克隆号
抗原
偶联物
形式
浓度
纯化类型
保存液
内含物
保存条件
运输条件
产品详细信息
For reconstitution, we recommend adding 100 µL distilled water to a final antibody concentration of about 1 mg/mL. To use this carrier-free antibody for conjugation experiments, we strongly recommend performing another round of desalting. (Zeba Spin Desalting Columns, 7KMWCO, 0.5 mL, Product # 89882)
靶标信息
A human dynamin-related protein, DRP1 contributes to mitochondrial division in mammalian cells. It plays this important role in mitochondrial fission at steady state and during apoptosis. DRP1 is required for proper cellular distribution of mitochondria, and in mutant neurons, mitochondria are largely absent from synapses, thus providing a genetic tool to assess the role of mitochondria at synapses.
仅用于科研。不用于诊断过程。未经明确授权不得转售。
篇参考文献 (0)
生物信息学
蛋白别名: Dnm1p/Vps1p-like protein; DVLP; Dymple; dynamin 1-like; Dynamin family member proline-rich carboxyl-terminal domain less; Dynamin-1-like protein; Dynamin-like protein; Dynamin-like protein 4; Dynamin-like protein IV; Dynamin-related protein 1; DYNIV 11; DYNIV-11; EC 3.6.5.5; FLJ41912; HdynIV; VPS1
基因别名: DLP1; DNM1L; DRP1; DVLP; DYMPLE; EMPF; HDYNIV
UniProt ID: (Human) O00429
Entrez Gene ID: (Human) 10059